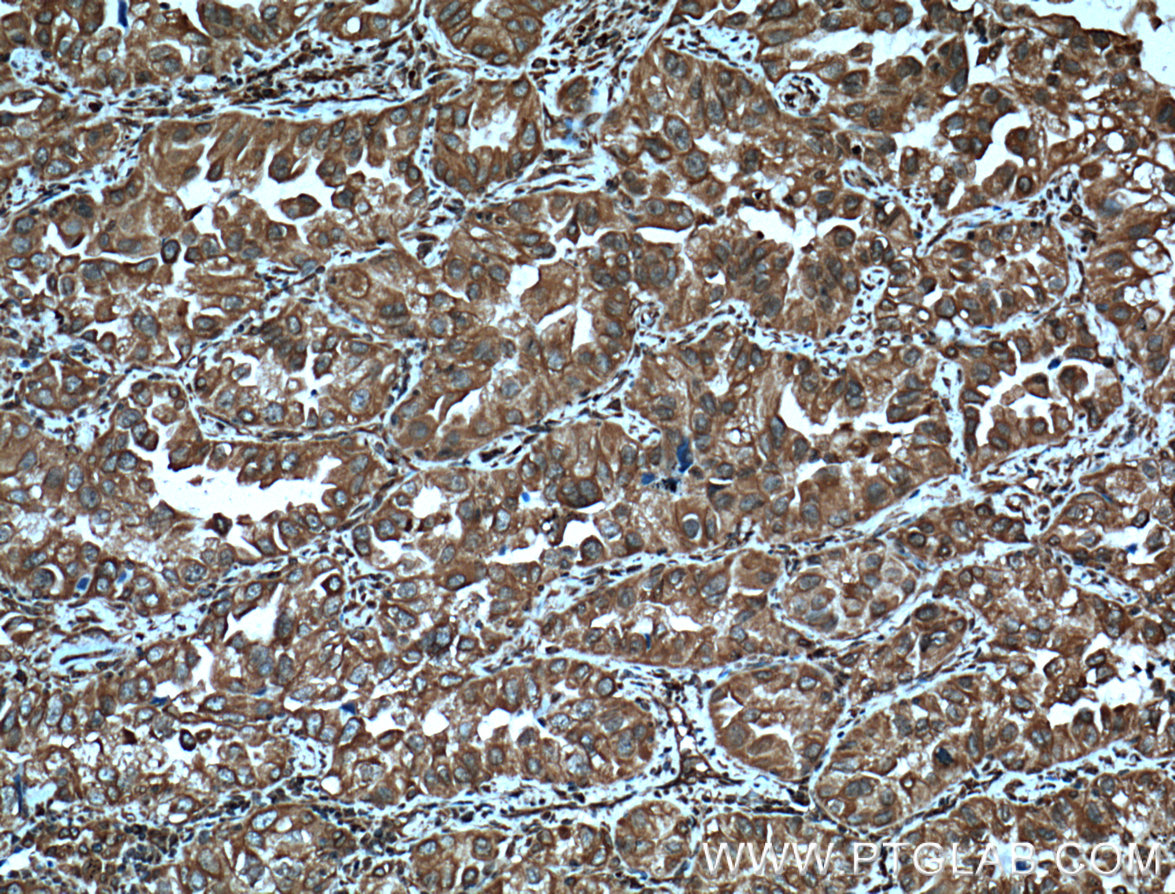

验证数据展示
经过测试的应用
| Positive WB detected in | Human heart, human heart tissue, human liver tissue, human lung tissue, NIH/3T3 cells, RAW 264.7 cells, ROS1728 cells |
| Positive IHC detected in | human lung cancer tissue, human breast cancer tissue Note: suggested antigen retrieval with TE buffer pH 9.0; (*) Alternatively, antigen retrieval may be performed with citrate buffer pH 6.0 |
| Positive IF/ICC detected in | HepG2 cells, Hela cells, MCF-7 cells |
推荐稀释比
| 应用 | 推荐稀释比 |
|---|---|
| Western Blot (WB) | WB : 1:500-1:2000 |
| Immunohistochemistry (IHC) | IHC : 1:50-1:500 |
| Immunofluorescence (IF)/ICC | IF/ICC : 1:50-1:500 |
| It is recommended that this reagent should be titrated in each testing system to obtain optimal results. | |
| Sample-dependent, Check data in validation data gallery. | |
发表文章中的应用
| WB | See 5 publications below |
| CoIP | See 1 publications below |
产品信息
60012-1-Ig targets GRP94 in WB, IHC, IF/ICC, CoIP, ELISA applications and shows reactivity with human, mouse, rat samples.
| 经测试应用 | WB, IF, IHC, ELISA Application Description |
| 文献引用应用 | WB, CoIP |
| 经测试反应性 | human, mouse, rat |
| 文献引用反应性 | human, mouse, rat |
| 免疫原 |
CatNo: Ag1439 Product name: Recombinant human GRP94 protein Source: e coli.-derived, PGEX-4T Tag: GST Domain: 1-315 aa of BC009195 Sequence: MRALWVLGLCCVLLTFGSVRADDEVDVDGTVEEDLGKSREGSRTDDEVVQREEEAIQLDGLNASQIRELREKSEKFAFQAEVNRMMKLIINSLYKNKEIFLRELISNASDALDKIRLISLTDENALSGNEELTVKIKCDKEKNLLHVTDTGVGMTREELVKNLGTIAKSGTSEFLNKMTEAQEDGQSTSELIGQFGVGFYSAFLVADKVIVTSKHNNDTQHIWESDSNEFSVIADPRGNTLGRGTTITLVLKEEASDYLELDTIKNLVKKYSQFINFPIYVWSSKTETVEEPMEEEEAAKEEKEESDDEAAARRR 种属同源性预测 |
| 宿主/亚型 | Mouse / IgM |
| 抗体类别 | Monoclonal |
| 产品类型 | Antibody |
| 全称 | heat shock protein 90kDa beta (Grp94), member 1 |
| 别名 | ECGP, GP96, GRP 94, GRP94, HSP90B1, TRA1, Tumor rejection antigen 1 |
| 计算分子量 | 96 kDa |
| 观测分子量 | 95 kDa |
| GenBank蛋白编号 | BC009195 |
| 基因名称 | GRP94 |
| Gene ID (NCBI) | 7184 |
| RRID | AB_2119056 |
| 偶联类型 | Unconjugated |
| 形式 | Liquid |
| 纯化方式 | Caprylic Acid-Ammonium Sulfate Precipitation |
| UNIPROT ID | P14625 |
| 储存缓冲液 | PBS with 0.02% sodium azide and 50% glycerol, pH 7.3. |
| 储存条件 | Store at -20°C. Stable for one year after shipment. Aliquoting is unnecessary for -20oC storage. |
背景介绍
HSP90 proteins are highly conserved molecular chaperones, which normally associate with other cochaperones and play important roles in folding newly synthesized proteins or stabilizing and refolding denatured proteins after stress. HSP90B1 (GP96 or GRP94) is an endoplasmic reticulum paralogue of the cytosolic HSP90. As a major ER chaperone to mediate the UPR and a master chaperone for Toll-like receptors (TLRs), HSP90b1 chaperones peptides to MHC class I molecules of dendritic cells and other antigen-presenting cells, as well as facilitating the assembly of immunoglobulin. The protein is also involved in many other bio-processes. This antibody was generated against the N-terminal region of full-length HSP90b1.
实验方案
| Product Specific Protocols | |
|---|---|
| FC protocol for GRP94 antibody 60012-1-Ig | Download protocol |
| IF protocol for GRP94 antibody 60012-1-Ig | Download protocol |
| IHC protocol for GRP94 antibody 60012-1-Ig | Download protocol |
| WB protocol for GRP94 antibody 60012-1-Ig | Download protocol |
| Standard Protocols | |
|---|---|
| Click here to view our Standard Protocols |
发表文章
| Species | Application | Title |
|---|---|---|
Autophagy Influenza M2 protein regulates MAVS-mediated signaling pathway through interacting with MAVS and increasing ROS production. | ||
Front Cell Dev Biol Extracellular Vesicles Carry lncRNA SNHG16 to Promote Metastasis of Breast Cancer Cells via the miR-892b/PPAPDC1A Axis. | ||
Cancer Sci Inhibition of heat shock protein 90 destabilizes receptor tyrosine kinase ROR1 in lung adenocarcinoma. | ||
Neurochem Res Novel Role of HAX-1 in Neurons Protection After Spinal Cord Injury Involvement of IRE-1. | ||
J Adv Res Development of a novel thymidylate synthase (TS) inhibitor capable of up-regulating P53 expression and inhibiting angiogenesis in NSCLC. | ||